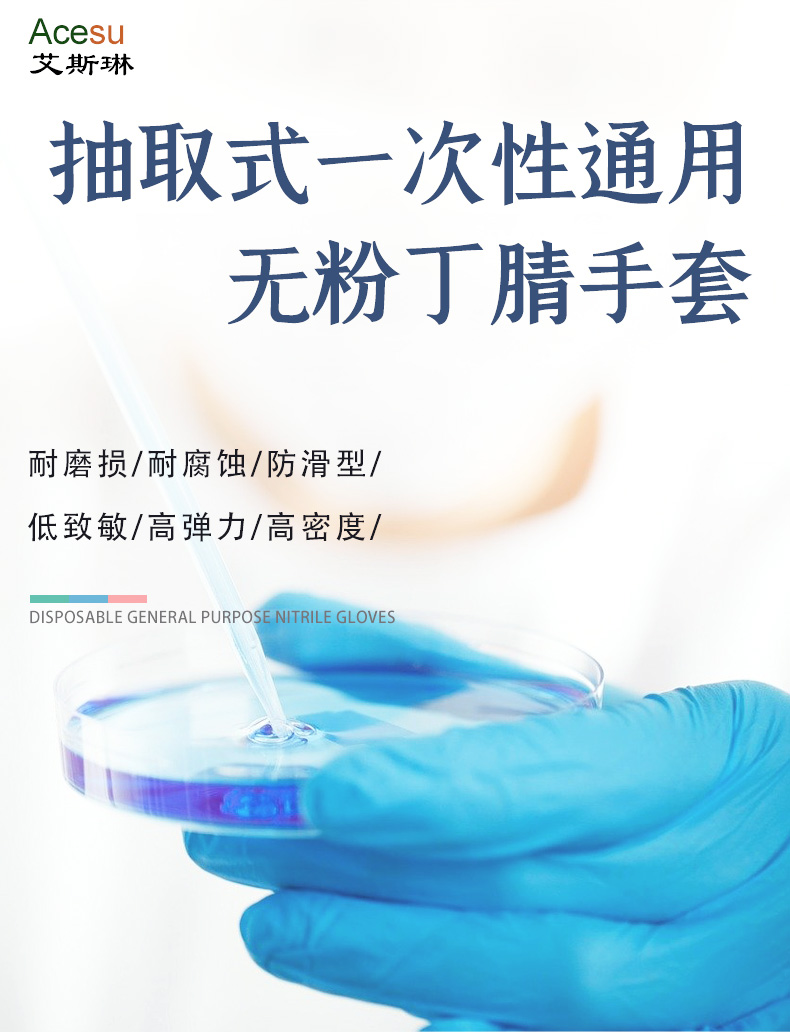

全部商品分类
生物培养
| 培养板
| 培养皿
| 培养瓶
| 刮刀/刮铲
| 细胞工厂
| 爬片
| 离心管
| 培养管
| 过滤网
| 冻存管
| 血清管/样品管
| 移液管
| 吸量管
| 吸头
| 过滤器
| 深孔板
| 储液槽
| 加样槽
| PCR管/板
| 接种环/针
| 阴道细菌检测板
| 样品库管
| 尿检管
| 涂布棒
| 接种棒
| 灭菌袋/牛皮纸
| 厌氧产气袋
| 离心管盒
| PCR封板膜
| 冻存盒
| 冻存盖子色标
| 离心管架
| PCR冰盒
| 磁力架
| 冻存架
| 盖玻片
| 深孔板封板膜
| 透析袋
| 透析袋夹子
| 病理刀片
| 制冷降温
| 酶标板/条
| 生物试剂
| 深孔板